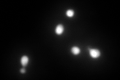
YLR354C
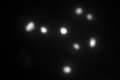
YLR354C

View description
Transaldolase, enzyme in the non-oxidative pentose phosphate pathway; converts sedoheptulose 7-phosphate and glyceraldehyde 3-phosphate to erythrose 4-phosphate and fructose 6-phosphate
Localization:
Intensity:
Fold change:
Significance:
-
C’ GFP library in SD
nucleus334.62 -
N' NOP1pr-GFP in SD

nucleus352.441 -
N' TEF2pr-mCherry in SD

nucleus397.379 -
N' NATIVEpr-GFP in SD

nucleus174.941 -
N' TEF2pr-VC and Cyto-VN in SD

#N/A0 -
C’ GFP library in SD+DTT

nucleus544.871.62Yes -
C’ GFP library in SD+H2O2

nucleus544.871.62Yes -
C’ GFP library in Starvation Media
nucleus622.641.86Yes -
C’ GFP library on the background of Pup2-DaMP

nucleus -
C’ GFP library on the background of CCT mutant

nucleus368.9221.10248No
